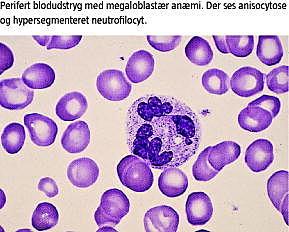

Vitamin B12 (B12 )-mangel opstår ved utilstrækkelig indtagelse af animalske fødeemner. Vegetarianerdiæt indeholder ikke kød, mens veganerdiæt også udelukker mælkeprodukter og æg. Voksne har et stort B12 -depot i leveren, hvorimod spædbørn og småbørn på grund af små reserver hurtigere end voksne vil udvikle mangelsymptomer ved utilstrækkelig tilførsel af B12 [1]. Som følge af B12 -mangel hos spædbørn, der er brysternæret af vegetarianer- og veganermødre, kan der opstå alvorlige hæmatologiske og neurologiske komplikationer.
Sygehistorier
I. En 12 måneder gammel dreng blev henvist pga. dårlig trivsel og forsinket udvikling. Vækst og udvikling var normal det første halve år, hvorefter vægten stagnerede, og barnet blev apatisk. Da barnet var 12 måneder gammelt, var det kun udviklet svarende til seks måneder. Begge forældre var veganere, og kosten indeholdt derfor ingen animalske fødeemner. På henvisningstidspunktet var drengen hypoton, passiv og psykomotorisk retarderet med en vægt på tipercentilen. Urinmetabolisk screening viste homocystein, og blodprøverne viste makrocytær anæmi, forhøjet blodplasma (p)-totalhomocystein og p-metylmalonat, lavt p-metionin og lave p-cobalaminer (Tabel 1 ). Moderens p-cobalamin var 140 pmol/l (140-543 pmol/l), mens faderens var 52 pmol/l. Drengen blev behandlet med cyanocobalamin 1 mg intramuskulært, initialt × 3 ugentligt, og efter to injektioner var p-totalhomocystein og p-metylmalonat normaliserede. Patienten blev mere aktiv, og hans megaloblastære anæmi forsvandt efter tre uger. Korrektion af B12 -manglen afslørede en jernmangelanæmi, som blev behandlet med jerntilskud. Patienten fik cyanocobalamin 1 mg intramuskulært tre gange ugentligt i halvanden måned og herefter 5 mg peroralt daglig. Der blev under sygdomsforløbet ikke foretaget magnetisk resonans (MR)-skanning af cerebrum, idet drengens cerebrale status var forklaret ud fra B12 -manglen. Ved kontrol et år efter var han psykomotorisk alderssvarende og i trivsel. Drengen fik fortsat veganerkost med tilskud af B12 .
II. En ti måneder gammel pige blev indlagt akut på grund af vægttab og tab af motoriske færdigheder. Hendes udvikling havde været normal indtil en måned før indlæggelsen. Barnet var brysternæret med forsøg på tilskud af fast føde i relation til aktuelle sygdomsperiode. Begge forældre var veganere både med hensyn til egen og barnets kost og tog intet vitamintilskud. Barnet var voksblegt, febrilt og hypotont. Blodprøver viste pancytopeni. Retikulocyttal, p-jern og p-ferritin var normale, og laktatdehydrogenase var svært forhøjet (Tabel 1). Behandling for urosepsis samt erytrocyttransfusioner blev institueret. Supplerende undersøgelser viste B12 -mangel med lav p-metionin, forhøjet p-totalhomocystein og p-metylmalonat samt homocystein- og metylmalonsyreudskillelse i urinen (Tabel 1). Knoglemarven viste udtalt megaloblastær anæmi. Moderens p-cobalaminer var 105 pmol/l. Barnet udviklede flere generaliserede krampeanfald. Elektroencefalogram var normalt. Computertomografi af cerebrum viste let central og kortikal atrofi.
Barnet fik cyanocobalamin 1 mg intramuskulært daglig i syv dage. Såvel hæmoglobin- som urinmetylmalonatudskillelsen samt p-metionin normaliseredes. Homocysteinudskillelsen i urinen ophørte. Familien ønskede ikke at ændre kosten fra veganerdiæt og udeblev fra aftalt kontrol.
Diskussion
På grund af lavt B12 -indhold i brystmælk er brysternærede børns tilskud af B12 begrænset det første leveår, hvorfor børnene er afhængige af, at B12 -depoterne i leveren er blevet opbygget intrauterint. Under normale omstændigheder er barnets B12 -depot sufficient på grund af placentar overgang. Dette forudsætter imidlertid normal B12 -status hos moderen. B12 -mangel hos spædbørn ses derfor overvejende hos brysternærede børn, der er født af mødre med B12 -mangel. Symptomerne inkluderer dårlig trivsel, hypotoni, forsinket motorisk udvikling og megaloblastær anæmi inden for de første 18 levemåneder. Den kognitive udvikling kan varigt reduceres [1].
Cobalamin virker som koenzym ved omdannelsen af homocystein til metionin og metylmalonyl-CoA til succinyl-CoA [2]. P-metylmalonat og p-totalhomocystein er derfor forhøjede ved B12 -mangel [3] og normaliseres hurtigt ved behandling med B12 .
Brystbørn, der er ernærede af veganermødre har risiko for at udvikle B12 -mangel med påvirket hæmatopoiese og degenerative nerveforandringer [1, 4]. Mens barnets megalocytære anæmi i løbet af dage remitterer på B12 -behandling, er nogle neurologiske skader blivende, herunder demyelinisering, der måske er forårsaget af cerebral metioninmangel [5]. Schenk et al [1] fandt, at seks børn, der blev diagnosticeret ti måneder gamle med B12 -mangel efter behandling, udviklede sig normalt, mens seks børn, der var diagnosticeret 13 måneder gamle, havde varige neurologiske skader på trods af behandling. Tidlig diagnostik af B12 -mangel er således vigtig. Diagnostikken af B12 -mangel hos spædbarnet inkluderer måling af p-cobalaminer, metylmalonat og aminosyrer, samt urinmetabolisk screening. Det er af afgørende betydning, at vegetarianere og veganere er opmærksomme på, at deres kosts indhold af B12 er insufficient. Af hensyn til fosteret og det diende barn er det nødvendigt, at moderen profylaktisk får B12 -tilskud i tabletform og som injektion ved manifest B12 -mangel. Denne behandling forebygger såvel den megaloblastære anæmi som den potentielt irreversible neurologiske skade.
Summary
Severe vitamin B12 deficiency in infants breastfed by vegans
Ugeskr Læger 2009;171(43):3099-3101
Weight loss and reduction of motor skills resulted in paediatric evaluation of a 10-month-old girl and a 12-month-old boy. Both children suffered form anaemia and delayed development due to vitamin B12 deficiency caused by strict maternal vegan diet during pregnancy and nursing. Therapy with cyanocobalamin was instituted with remission of symptoms. Since infants risk irreversible neurologic damage following severe vit amin B12 deficiency, early diagnosis and treatment are mandatory. Vegan and vegetarian women should take vitamin B12 supplementation during the pregnancy and nursing period.
Casper Roed, Dronningens Tværgade 46, 2. sal, DK-1302 København K. E-mail: casper.roed@rh.regionh.dk
Antaget: 12. december 2007
Interessekonflikter: Ingen
<ol class="Litt-list">
<li>Schenck U, Bender-Gøtze C, Koletzko B. Persistence of neurological damage induced by dietary vitamin B12 deficiency in infancy. Arch Dis Child 1997;77:137-39.</li>
<li>Allen RH, Stabler SP, Savage DG et al. Metabolic abnormalities in cobalamin (vitamin B12) and folate dificiency. FASEB Jour 1993;7:1344-53.</li>
<li>3. Monsen ALB, Ueland PM. Homocysteine and methylmalonic acid in diagnosis and risk assessment from infancy to adolescence. Am Jour Clin Nutr 2003;78:7-21.</li>
<li>Weiss R, Fogelman Y, Bennett M. Severe vitamin B12 deficiency in an infant associated with a maternal deficiency and a strict vegetarian diet. J Pediat Hematol Oncol 2004;26:270-1.</li>
<li>Molloy AM, Weir DG. Homocysteine and the nervous system. I: Carmel R, Jacobsen DW, red. Homocysteine in Health and Disease. Cambridge: University Press, 2001: 34-34.</li>
</ol>
Summary Severe vitamin B12 deficiency in infants breastfed by vegans Ugeskr Læger 2009;171(43):3099-3101 Weight loss and reduction of motor skills resulted in paediatric evaluation of a 10-month-old girl and a 12-month-old boy. Both children suffered form anaemia and delayed development due to vitamin B12 deficiency caused by strict maternal vegan diet during pregnancy and nursing. Therapy with cyanocobalamin was instituted with remission of symptoms. Since infants risk irreversible neurologic damage following severe vitamin B12 deficiency, early diagnosis and treatment are mandatory. Vegan and vegetarian women should take vitamin B12 supplementation during the pregnancy and nursing period.